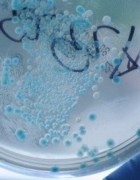

Dooderm
Textile technique à base de fil d’argent et vêtements apaisants et antibactériens : Dooderm, une marque innovante pour les peaux Lire la suite
L’innovation en long, en large et en travers: des (bonnes) idées, de l’économie, un peu de politique d’innovation, de la R&D, du transfert de technologie, des exemples de clusters et de pôles de compétitivité, de la smart economy pour rendre le tout sexy, l’envie de créer de la valeur et de la croissance, un état de lieux en Europe, en France et dans le monde…

Textile technique à base de fil d’argent et vêtements apaisants et antibactériens : Dooderm, une marque innovante pour les peaux Lire la suite
Antibiotiques et antibiorésistance: un défi global ! 25000 décès par an en Europe aujourd’hui, 50 millions de morts attendus dans Lire la suite

Hommage au patrimoine toulousain et nouvelle approche de la cosmétique : Graine de Pastel valorise les actifs issus d’Isatis tinctoria Lire la suite

Un Musée des Arts contemporains différent, entre héritage et création, architecture et design. Entre MONS2015 et Borinage, retour vers le Lire la suite

Retour sur BIOVISION 2013, Forum international et biennal qui proposait fin mars à Lyon un tour d’horizon sur fond de Lire la suite

WIC 2012: Du Rêve européen à la nouvelle donne mondiale: what’s on ? 10 ans, plus de 350 participants, 30 Lire la suite